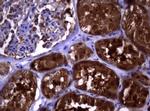
PIK3C2A Antibody in Immunohistochemistry (Paraffin) (IHC (P))

Search
OriGene
PIK3C2A Monoclonal Antibody (OTI2C11), TrueMAB™
{{$productOrderCtrl.translations['antibody.pdp.commerceCard.promotion.promotions']}}
{{$productOrderCtrl.translations['antibody.pdp.commerceCard.promotion.viewpromo']}}
{{$productOrderCtrl.translations['antibody.pdp.commerceCard.promotion.promocode']}}: {{promo.promoCode}} {{promo.promoTitle}} {{promo.promoDescription}}. {{$productOrderCtrl.translations['antibody.pdp.commerceCard.promotion.learnmore']}}
产品信息
CF801725
种属反应
宿主/亚型
分类
类型
克隆号
抗原
偶联物
形式
浓度
规格
纯化类型
保存液
内含物
保存条件
运输条件
产品详细信息
For reconstitution, we recommend adding 100 µL distilled water to a final antibody concentration of about 1 mg/mL. To use this carrier-free antibody for conjugation experiments, we strongly recommend performing another round of desalting. (Zeba Spin Desalting Columns, 7KMWCO, 0.5 mL, Product # 89882)
靶标信息
The Class II PI3 kinases, including PIK3C2A, phosphorylate the 3 position of PI or PI4P. Though not as well studied as the Class I PI3 kinases, the Class II enyzmes have been linked to diverse, receptor-mediated cellular processes including insulin signaling, neuronal survival, and growth factor signaling. PI3-kinases play roles in signaling pathways involved in cell proliferation, oncogenic transformation, cell survival, cell migration, and intracellular protein trafficking. This protein contains a lipid kinase catalytic domain as well as a C-terminal C2 domain, a characteristic of class II PI3-kinases. C2 domains act as calcium-dependent phospholipid binding motifs that mediate translocation of proteins to membranes, and may also mediate protein-protein interactions. The PI3-kinase activity of this protein is not sensitive to nanomolar levels of the inhibitor wortmanin. This protein was shown to be able to be activated by insulin and may be involved in integrin-dependent signaling.
仅用于科研。不用于诊断过程。未经明确授权不得转售。
篇参考文献 (0)
生物信息学
蛋白别名: C2-containing phosphatidylinositol kinase; DKFZp686L193; MGC142218; Phosphatidylinositol 4-phosphate 3-kinase C2 domain-containing subunit alpha; phosphatidylinositol-4-phosphate 3-kinase C2 domain-containing subunit alpha; Phosphoinositide 3-kinase-C2-alpha; phosphoinositide-3-kinase, class 2, alpha polypeptide; PI3K-C2-alpha; pi3kc2a; ptdIns-3-kinase C2 subunit alpha; unnamed protein product
基因别名: CPK; OCSKD; PI3-K-C2(ALPHA); PI3-K-C2A; PI3K-C2-alpha; PI3K-C2alpha; PIK3C2A
UniProt ID: (Human) O00443
Entrez Gene ID: (Human) 5286